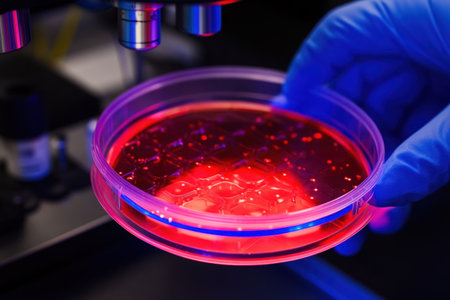
A close-up of a 96-well plate being used in medical research, with the focus on one well containing red liquid and another blue ink. The background shows laboratory equipment like micropipettes or digital microscopes. A scientist's hand is visible, wearing gloves and holding up the plate to display it under the light for closer inspection. The scene conveys scientific precision and attention to detail during advanced chemical experimentation. --ar 3:2 --v 6.1 Job ID: 5e43244c-e3de-4b35-96cd-0951191be7a3の素材

素材 - A close-up of a 96-well plate being used in medical research, with the focus on one well containing red liquid and another blue ink. The background shows laboratory equipment like micropipettes or digital microscopes. A scientist's hand is visible, wearing gloves and holding up the plate to display it under the light for closer inspection. The scene conveys scientific precision and attention to detail during advanced chemical experimentation. --ar 3:2 --v 6.1 Job ID: 5e43244c-e3de-4b35-96cd-0951191be7a3
作品情報
A close-up of a 96-well plate being used in medical research, with the focus on one well containing red liquid and another blue ink. The background shows laboratory equipment like micropipettes or digital microscopes. A scientist's hand is visible, wearing gloves and holding up the plate to display it under the light for closer inspection. The scene conveys scientific precision and attention to detail during advanced chemical experimentation. --ar 3:2 --v 6.1 Job ID: 5e43244c-e3de-4b35-96cd-0951191be7a3
- ID:262929168
- 作品種別:
- 作者名:Alfath Grafis
キーワード
- agar
- analysis
- biology
- blue
- cells
- closeup
- culture
- detail
- development
- diagnosis
- discovery
- dish
- examination
- experiment
- experimentation
- fluid
- genetics
- gloved
- gloves
- growth
- hand
- healthcare
- illumination
- innovation
- investigation
- laboratory
- light
- liquid
- medical
- medicine
- microscope
- petri
- professional
- red
- research
- researcher
- sample
- science
- scientific
- scientist
- technology
- testing
- treatment
類似作品
refueling a car...
66 old iron roa...
Happy New Year ...
Girl on the bea...
A Scary Door Wi...
House number 99...
Picture of a wo...
Futuristic cybe...
Glowing 3D Numb...
The number 99 p...
House number ei...
Ft. Wayne - Cir...
A Written Wordi...
Neon Number 85,...
Old American st...
5G and 6G mobil...
Solid number 89...
Number 69 Compo...
Number 99
View of a metal...
Red dart arrow ...
front plaque of...
Silver scattere...
birthday cupcak...
Man looks throu...
Birthday cupcak...
Tourist man tak...
A beach huts in...
number 8
The number 87 o...
Front of big ye...
Blue Glowing Di...
Glowing Digital...
An historic sto...
House number ei...
Glowing Neon Nu...
House number ni...
Birthday cupcak...
AI Generative H...
house number ni...
Black and white...
Bleacher view l...
Enameled house ...
house number ni...
Image of proces...
Birthday cupcak...
Hand holding pa...
Glowing Digital...
Neon 18 sign on...